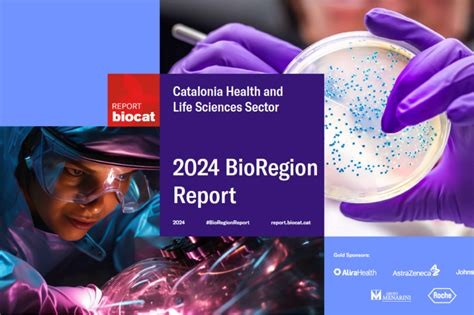
2024 Catalonia BioRegion Report

Platinum Sponsors
Platinum Sponsors
Platinum Sponsors
BIOSPAIN 2025 Recap
About BIOSPAIN
BIOSPAIN is the largest biotech event organized by a national bioindustry association in Europe and one of the largest in the world by the number of one-to-one meetings and companies participating. 34% of our delegates came from outside of Spain.
This year, BIOSPAIN goes back to Barcelona, the main biotech cluster in Spain and one of the most dynamic cities in the world.
The event will take place in Pavilion 1 – Fira de Barcelona – Montjuïc. It stands in a superb location in the city center, easily accessible from the airport and well-connected to the public transport network. It is located in Montjuïc Park, an area of cultural and historical interest thanks to its museums and theatres and it also features some of the main tourist attractions in Barcelona.
![]()
Scam Warning
There are an increasing number of fake websites claiming to offer database of Biospain participants. Biospain does NOT sell any personal details.
We would like to alert all participants to be aware of possible scams.
Ways to participate
Register
as Delegate
as Delegate
Book a
Booth
Booth
Sponsor
the Event
the Event
Record result
Why Spain?
Nearly 4,500 companies carried out biotechnology activities in 2023, of which 974 were biotech firms.
47% of biotech firms working exclusively in biotechnology do so in human health, followed by those focused on food applications, at 42%.
In terms of geographic breakdown, Catalonia, Madrid, Andalusia and the Basque Country are home to the largest number of companies. Catalonia leads in number of biotech companies in Spain, with almost a quarter of the total and more than 35% of total turnover.
The joint activity of biotech companies generated in 2022 over €19,676 billion in revenue, and generated a gross value added of € 6.8 billion.



The science produced by the Spanish biotechnology sector is excellent and its innovation is patented internationally.
In 2022, Spanish scientific production in biotechnology made up 2.46% of global production and was cited 21% more than the global average. Spain remains ranked ninth in the world in number of papers in biotechnology.
Technological innovation is being protected more and more internationally. Patents through PCT and the European Patent Office make up 82% of all patent applications.
In 2023, we identified 96 new products launched to market by AseBio member companies.
The sector is working together to tackle the pandemic and maintains its interest in international markets.
Biotech firms forged 332 partnerships and 224 of them were with public entities and foundations. R&D is the main goal for companies seeking out strategic partnerships, with this being the main goal in 84% of all partnerships. In terms of country of origin, the number of international partners was up 10% from the previous year.
AseBio member companies increased internationalization 8%, with 16 new subsidiaries. 43 member companies have a direct presence in 59 countries on all continents.
Social perception of Biotechnology in Spain
According to the Survey on Social Perception of Innovation, more than 80% of the population sees innovation as positive, up nearly 8% over the previous year. Plus, public perception still puts Spanish innovation on par with the European Union average.
Public opinion of biotechnology remains the most highly rated factor among AseBio members. On the other hand, the economic situation remains the main barrier in the sector, along with the regulatory framework, which has been negatively affected by changes implemented in 2023.
In 2022, Spanish scientific production in biotechnology made up 2.46% of global production and was cited 21% more than the global average. Spain remains ranked ninth in the world in number of papers in biotechnology.
Technological innovation is being protected more and more internationally. Patents through PCT and the European Patent Office make up 82% of all patent applications. In 2023, we identified 96 new products launched to market by AseBio member companies.
About the host city -region
Catalonia stands as one of Europe’s most dynamic life sciences and healthcare innovation ecosystems. The BioRegion, primarily centered in Barcelona, comprises over 1,500 companies and 93 research institutions, supported by leading universities, hospitals, and research centers. This vibrant ecosystem attracts talent, startups, investors, and multinational corporations dedicated to advancing health innovation.
The life sciences and healthcare sector contributes 7.6% to Catalonia’s GDP and employs over 280,000 individuals, accounting for 7.3% of the working population. In 2024, the region achieved a new record €347 million in investment for health startups and scaleups, marking the second-highest figure in its history. Foreign direct investment also reached a notable €550 million, leading to the creation of nearly 1,700 new jobs.
Catalonia ranks 5th in Europe and 8th globally for active clinical trials, with 5,368 ongoing studies (participates in 87% of Spanish trials). The region is also a leader in scientific production: Catalonia ranks 5th in publications and 1st in Highly Cited Papers (per mhab) in Europe. The clinical pipeline features a dynamic activtiy, with 75 molecules in development (21 in Advanced Therapies), 65% of which are in advanced stages (II and III). Additionally, 112 health startups and scaleups are actively working on applications of AI in healthcare.
With a proven track record of innovation, international collaboration, and sustained growth, the BioRegion of Catalonia offers an exceptional environment for hosting BIOSPAIN 2025
About the host city -region
Catalonia stands as one of Europe’s most dynamic life sciences and healthcare innovation ecosystems. The BioRegion, primarily centered in Barcelona, comprises over 1,500 companies and 93 research institutions, supported by leading universities, hospitals, and research centers. This vibrant ecosystem attracts talent, startups, investors, and multinational corporations dedicated to advancing health innovation.
The life sciences and healthcare sector contributes 7.6% to Catalonia’s GDP and employs over 280,000 individuals, accounting for 7.3% of the working population. In 2024, the region achieved a new record €347 million in investment for health startups and scaleups, marking the second-highest figure in its history. Foreign direct investment also reached a notable €550 million, leading to the creation of nearly 1,700 new jobs.
Catalonia ranks 5th in Europe and 8th globally for active clinical trials, with 5,368 ongoing studies (participates in 87% of Spanish trials). The region is also a leader in scientific production: Catalonia ranks 5th in publications and 1st in Highly Cited Papers (per mhab) in Europe. The clinical pipeline features a dynamic activtiy, with 75 molecules in development (21 in Advanced Therapies), 65% of which are in advanced stages (II and III). Additionally, 112 health startups and scaleups are actively working on applications of AI in healthcare.
With a proven track record of innovation, international collaboration, and sustained growth, the BioRegion of Catalonia offers an exceptional environment for hosting BIOSPAIN 2025
Left

AM Conferences & Meetings